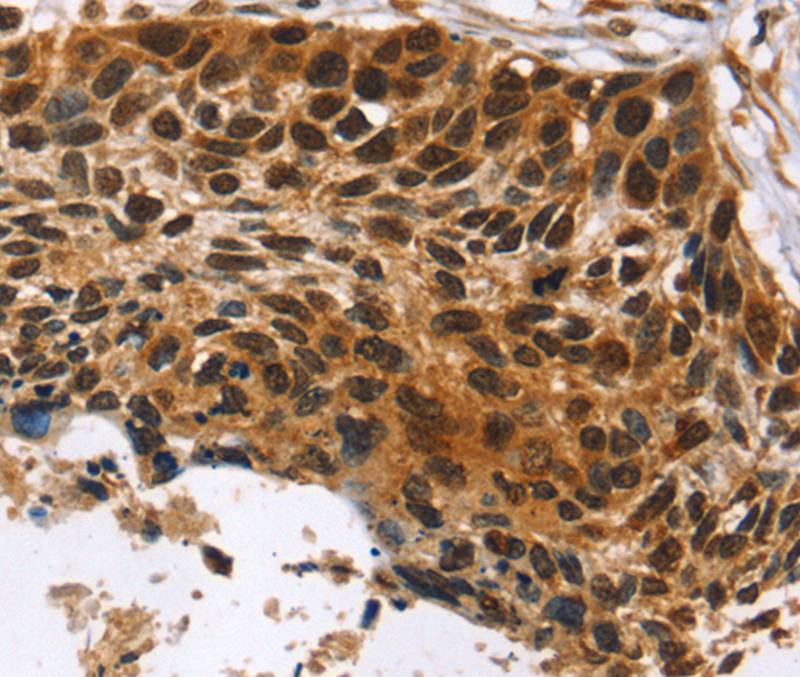

Western Blot Positive WB detected in: HepG2 whole cell lysate All lanes: CDX1 antibody at 1:2000 Secondary Goat polyclonal to rabbit IgG at 1/50000 dilution Predicted band size: 29, 15 kDa Observed band size: 25-30 kDa
CDX1 Recombinant Monoclonal Antibody
CSB-RA987794A0HU
ApplicationsImmunoFluorescence, Western Blot, ELISA
Product group Antibodies
TargetCDX1
Overview
- SupplierCusabio
- Product NameCDX1 Recombinant Monoclonal Antibody
- Delivery Days Customer20
- ApplicationsImmunoFluorescence, Western Blot, ELISA
- CertificationResearch Use Only
- ClonalityMonoclonal
- Clone ID11E10
- ConjugateUnconjugated
- Gene ID1044
- Target nameCDX1
- Target descriptioncaudal type homeobox 1
- Target synonymscaudal type homeo box transcription factor 1; caudal type homeobox transcription factor 1; caudal-type homeobox protein 1; caudal-type homeobox protein CDX1; homeobox protein CDX-1
- IsotypeIgG
- Protein IDP47902
- Protein NameHomeobox protein CDX-1
- Storage Instruction-20°C or -80°C
- UNSPSC12352203